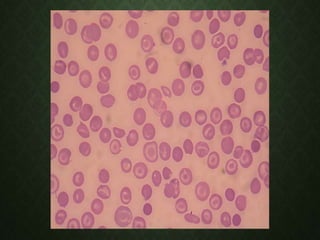
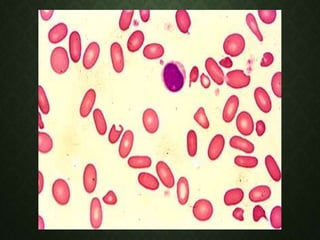

El documento describe la deficiencia de hierro y la anemia ferropénica. La deficiencia de hierro ocurre cuando las necesidades o pérdidas de hierro superan la capacidad del organismo para absorber hierro de los alimentos. Esto puede deberse a una ingesta inadecuada, pérdidas sanguíneas o requerimientos elevados de hierro. La anemia ferropénica se caracteriza por eritrocitos pequeños y pálidos, y niveles bajos de ferritina sérica. El tratamiento incluye la suplementación oral o intravenosa

![• Pueden observarse eliptocitos hipocrómicos elongados,
denominados “células en lápiz” aunque también parecen puros.
• Los índices de glóbulos rojos estas alterados en los adultos solo
cuando la anemia es moderada o grave:
• [12 g/dl] hemoglobina en hombres.
• [10 g/dl] hemoglobina en mujeres.](https://image.slidesharecdn.com/anemiaporferropenica-140710162610-phpapp01/85/Anemia-Ferropenica-37-320.jpg)








![CAPACIDAD DE FIJACIÓN DEL HIERRO
Y SATURACIÓN DE TRANSFERRINA.
• Es una medida de la cantidad de transferrina en sangre.
• Normalmente existe suficiente transferrina para ligar:
• 4,4 a 8,0 µmol (250 a 450 µg) de hierro; la [ ] normal de hierro es de
1,8 µmol/dl.
• La transferrina esta saturada en un tercio con hierro.
• La capacidad latente de unión al hierro se mide con hierro
radioactivo o por técnicas espectrofotométricas.
• Normalmente la transferrina esta saturada entre 20% al 50% con
hierro.
• En la deficiencia de hierro las capacidad total y latente de unión al
hierro están aumentadas.](https://image.slidesharecdn.com/anemiaporferropenica-140710162610-phpapp01/85/Anemia-Ferropenica-46-320.jpg)























